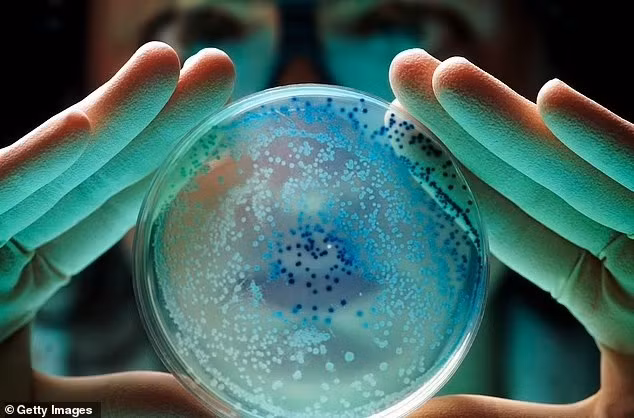
tram-vu-tru-trung-quoc-bat-ngo-chua-vi-khuan-chua-tung-biet-den-tren-trai-dat2.jpg

Trong nỗ lực tìm kiếm sự sống ngoài Trái Đất, các nhà khoa học đã bất ngờ phát hiện một loài vi khuẩn hoàn toàn mới, chưa từng được biết đến trên Trái đất, đang sống ngay bên trong trạm vũ trụ Tiangong của Trung Quốc.
Loài vi khuẩn này được đặt tên Niallia tiangongensis, theo tên trạm Tiangong, và có họ hàng gần với vi khuẩn sống trong đất có tên Niallia circulans.
Tuy nhiên, điểm đặc biệt của Niallia tiangongensis là đã tiến hóa để thích nghi với điều kiện khắc nghiệt của không gian, nơi có bức xạ cao và môi trường nghèo dưỡng chất.
Các nhà nghiên cứu cho biết vi khuẩn mới sở hữu những gen đặc biệt giúp sửa chữa tổn thương do bức xạ ngoài khí quyển Trái đất gây ra. Đáng chú ý, chúng còn có khả năng “ăn” gelatin để tạo ra lớp màng sinh học (biofilm) dày, giúp bảo vệ khỏi môi trường khắc nghiệt.
Hiện chưa rõ Niallia tiangongensis có gây nguy hiểm cho con người hay không, dù loài họ hàng gần trên Trái Đất, Niallia circulans, được biết có thể gây nhiễm trùng huyết (sepsis) ở người có hệ miễn dịch suy yếu.
Cả 2 loại đều có khả năng tạo bào tử, giúp sống sót trong điều kiện khắc nghiệt và phát tán dễ dàng.
Vi khuẩn mới được tìm thấy qua các mẫu vật thu thập bởi phi hành đoàn nhiệm vụ Shenzhou-15 năm 2023. Phi hành gia đã dùng khăn tiệt trùng lau các bức tường trong khoang, rồi cấp đông mẫu để mang về Trái đất phân tích.
Trước đây, NASA cũng từng phát hiện 13 chủng vi khuẩn kháng thuốc mới sống trên trạm vũ trụ quốc tế (ISS), bám trong khe thông gió, thiết bị tập luyện và nhà vệ sinh. Theo các nhà khoa học, những vi khuẩn này vốn là chủng Trái đất nhưng đã tiến hóa khi sống lâu trong môi trường không gian.
Dù các cơ quan vũ trụ luôn nỗ lực tránh lây nhiễm vi khuẩn vào các trạm và tàu vũ trụ, việc kiểm soát hoàn toàn là gần như không thể.
NASA từng phát hiện tới 53 chủng vi khuẩn trong các phòng sạch dùng để chuẩn bị cho tàu đổ bộ Phoenix lên sao Hỏa, trong đó có 26 loài chưa từng được biết đến.
Sức sống phi thường của vi khuẩn khiến NASA phải thực hiện cả nhiệm vụ ngoài trạm ISS để xác định liệu có vi khuẩn sống sót ngoài chân không vũ trụ.
Vấn đề này càng trở nên cấp thiết khi Trung Quốc và Mỹ đều đang theo đuổi mục tiêu thiết lập căn cứ lâu dài trên Mặt trăng. Trong không gian kín và xa Trái Đất, việc vi khuẩn lạ – đặc biệt là chủng kháng kháng sinh – lan rộng có thể gây nguy cơ lớn cho phi hành đoàn.
Trớ trêu thay, môi trường quá sạch trong các trạm vũ trụ lại vô tình tạo điều kiện cho một số loài vi khuẩn “siêu chịu đựng” phát triển không bị cạnh tranh.
NASA phát hiện nhiều phi hành gia trên ISS thường bị nổi mẩn, lở miệng, có thể do vi khuẩn da của chính họ phát triển mạnh trên tường khoang vì thiếu sự cạnh tranh từ vi sinh vật khác.
Nếu nhân loại thực sự muốn hiện diện lâu dài trong không gian, thì việc kiểm soát và quản lý sự tiến hóa của vi khuẩn trong môi trường vũ trụ sẽ là thách thức không thể bỏ qua.





































